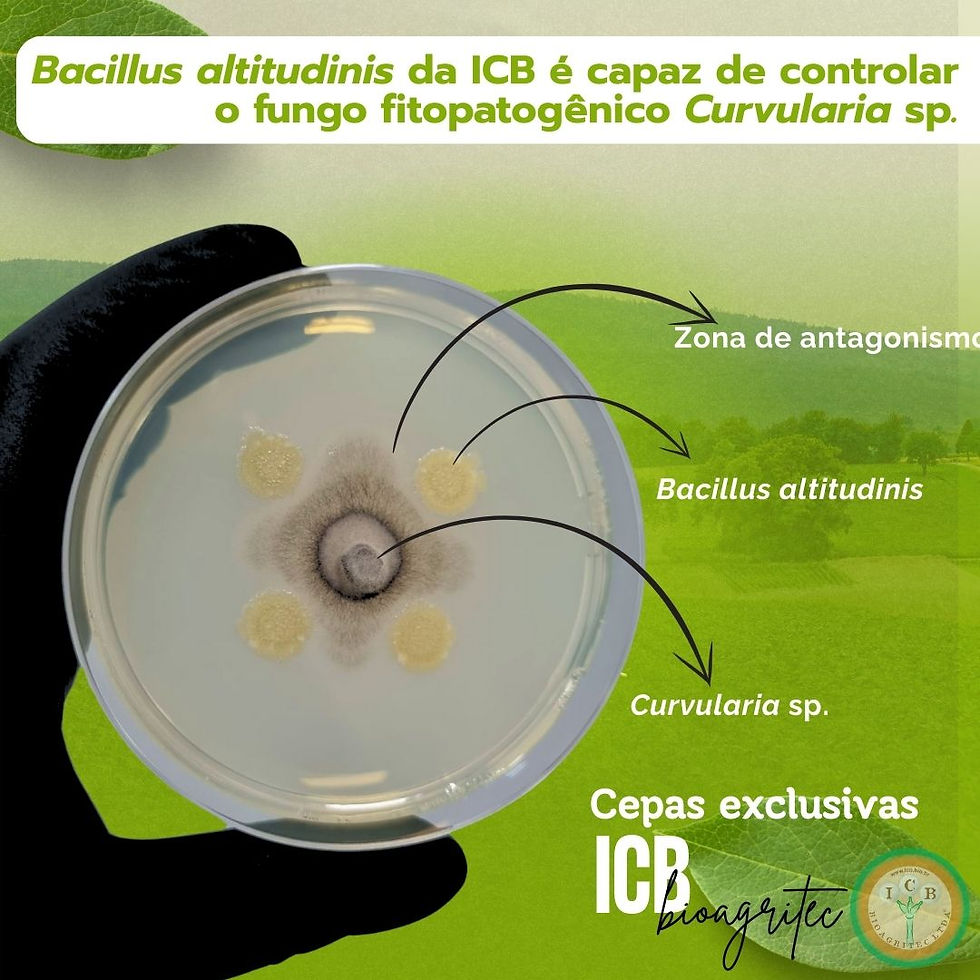
IMG-20250501-WA0009

Bioinsumos para lavouras produtivas
Trabalhamos com a linha de produtos da ICB BIOAGRITEC Ltda, pioneira na indústria de bioformulados de produção massal..
​
Banco de cepas próprio
Atualmente a empresa conta com um banco de cepas próprio com coleções de fungos e bactérias, de ampla distribuição geográfica, selecionadas, identificadas taxonomicamente e preservadas. Idealizou e implementou uma tecnologia própria para prospectar novos formulados biológicos que possibilitam a otimização do potencial biotecnológico do produto final.
Na foto, uma amostra da morfologia de algumas colônias fúngicas e bacteriana, crescidas em placas de petri com meio de cultivo específico para cada espécie, presentes no banco.

Agrozini Bioinsumos
@agrozini.bio
+55 (44) 9 9961-1311 (Maringá e demais regiões)
+55 (42) 9 9911-8838 (Campos Gerais)
Paraná - Brasil
©2021 por Agrozini Bioinsumos



